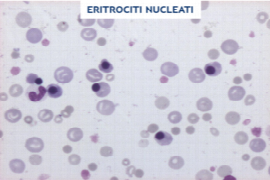

Gabriele Rossi
DVM, PhD, Diplomate ECVCP

Gabriele Rossi
DVM, PhD, Diplomate ECVCP
Gabriele Rossi is a Senior Lecturer in Veterinary Clinical Pathology at Murdoch University in Perth (Western Australia). Gabriele graduated in Italy at University of Milan. After completion a PhD focused on investigation of new diagnostic biomarkers in different veterinary species, he passed the European College of Veterinary Clinical Pathology board. Gabriele is teaching different areas of veterinary clinical pathology to undergraduate veterinary students and he is actively involved in continuing education for veterinarians’ nurses and veterinarians. Gabriele’s research interests include anemia, sepsis and renal diseases.
Webinare

Gary England
DVM, BvetMed, PhD, DvetMed, DVR, CertVA, DVRep, Dipl ACT, Dipl ECAR, FHEA, FRCVS

Gary England
DVM, BvetMed, PhD, DvetMed, DVR, CertVA, DVRep, Dipl ACT, Dipl ECAR, FHEA, FRCVS
Gary England is the Foundation Dean of the School of Veterinary Medicine and Science and is Professor of Comparative Veterinary Reproduction.
He is a Fellow of the Royal College of Veterinary Surgeons, and is recognised as a Specialist in Veterinary Reproduction by the Royal College and the European College of Animal Reproduction. He is a Diplomate of the American College of Theriogenologists.
Gary was part of the team responsible for developing the new veterinary curriculum at Nottingham. He is a Principal Fellow of the Higher Education Academy and is an active teacher and clinician, working in animal reproduction and diagnostic imaging.
Webinare

Gary Fitzgerald
BVetTech

Gary Fitzgerald
BVetTech
Gary graduated from the University of Queensland Veterinary Technology program in 2006. Since graduation, he has worked in general practice, specialist referral and teaching positions. He now holds the position of Nurse Manager for the University of Queensland Veterinary Teaching Hospitals (UQ VETS). In this role, he manages a large number of nursing and technician staff across the Small animal, Equine and Production animal teaching hospitals.
Gary is strong advocate for nurse and technician continuing professional development. He has lectured at national and international conferences and is a RECOVER advanced life support instructor. He also holds committee positions for both the Australian Veterinary Nurse and Technician (AVNAT) registration scheme and the Veterinary Nurse Council of Australia (VNCA) QLD division.
He enjoys all aspects of his job but mentoring staff, training students, small animal anaesthesia and critical care and exotic animal medicine, anaesthesia and surgery are his major passions.
Webinare

Gemma Fraga Veloso
DipECVIM-CA (Cardio), MRCVS

Gemma Fraga Veloso
DipECVIM-CA (Cardio), MRCVS
Gemma se ha graduado en la Facultad de Medicina de la Universidad Cardenal Herrera-CEU of Valencia (Spain) en 2003. Ha estado varios meses en clínica privada hasta ser admitida en la Facultad Veterinaria de Lugo en la Universidad de Santiago de Compostela (España) donde hice un internado de dos años en el Hospital Veterinario Rof Codina.
De seguida ha terminado un master en Medicina de pequeños animales y de animales exóticos y ha obtenido el Diploma de Estudios Avanzados en la Universidad de Santiago de Compostela. Hice también un externado en Cornell University and Ohio State University.
En diciembre de 2010 ha terminado su residencia en Medicina Cardiopulmonar en el hospital de pequeños animales de la Universidad de Edinburgh.
Webinare

Georg Duscher
Priv.-Doz., DVM

Georg Duscher
Priv.-Doz., DVM
- Geboren in Linz, Studium der Biologie/Zoologie in Wien bis 2001
- Promotion an der Parasitologie der VetMedUni Wien 2005
- 2002-2019 Assistent an der VetMedUni Wien - Parasitologie
- seit 2019 Fachexperte für Zoonosen bei der AGES (Österreichische Agentur für Gesundheit und Ernährungssicherheit GmbH); Spezialisierungen: Zecken und andere Vektoren
wissenschaftliche Leistungen:
Am 14.12.2015 wurde die Lehrbefugnis für das Fach Parasitologie ausgestellt (Habilitation).
Habilitationsthema: Schildzecken und durch Schildzecken übertragene Erreger in Österreich: Aspekte der Zecken- und Erregerarten sowie Strategien zur Zeckenkontrolle.
Bis dato 81 Originalartikel in peer reviewed journals.
Seit 1.10.2019 zuständig für das Forschungsservice im Bereich Veterinärmedizin/Zoonosen bei der AGES.
Präsident der Österreichischen Gesellschaft für Tropenmedizin, Parasitologie und Migrationsmedizin, Vizepräsident des Vereins zur Förderung der Impfaufklärung.
Webinare

Georg von Samson-Himmelstjerna
Prof. DVM

Georg von Samson-Himmelstjerna
Prof. DVM
Georg von Samson-Himmelstjerna ist als Universitätsprofessor (W3) am Institut für Parasitologie und Tropenveterinärmedizin (IPTVM), Freie Universität Berlin tätig.
Er studierte Veterinärmedizin an der Tierärztlichen Hochschule Hannover (TiHo). Nach der Promotion 1995 war er zunächst leitender Mitarbeiter der Bayer AG Leverkusen, bevor er 2001 als Leiter der Arbeitsgruppe molekulare Parasitologie an das Institut für Parasitologie der TiHo wechselte.
Er habilitierte im Fachgebiet Parasitologie an der TiHo 2003 und wurde 2005 zum Universitätsprofessor (W2) für Molekulare Parasitologie an der TiHo ernannt. Seit Oktober 2009 ist er der Geschäftsführende Direktor des IPTVM. Seine Forschungsschwerpunkte beinhalten die molekulare Untersuchung der Wirk- und Resistenzmechanismen neuer und etablierter Antiparasitika.
Er ist Autor bzw. Co-Autor von mehr als 200 Publikationen in internationalen wissenschaftlichen Zeitschriften sowie Mitherausgeber des ‘Lehrbuchs der Parasitologie für die Tiermedizin‘.
Seit 2012 ist er Vorsitzender der deutschen Sektion des European Scientific Counsel Companion Animal Parasites (ESCCAP).
Webinare

George Sofronidis
BSc (Hons)

George Sofronidis
BSc (Hons)
George Sofronidis has over 20 years of dedicated experience in molecular biology and the way it can assist in areas of human and animal management. Following his initial work and research in forensic science at the Victorian Institute of Forensic Medicine and human diagnostics he moved his focus into the area of animal reproduction and conservation. George has worked at Monash University, Melbourne University and the Zoological Parks and Gardens Board. His strong appreciation for the benefits animals bring to our society saw George in 2000 establish Genetic Science Services, a company dedicated to bringing animals into the DNA testing revolution. George joined and managed the Animal Division at Genetic Technologies in 2003 managing facilities locally and in the Asia Pacific Region. George has developed a respected canine testing business and in October of 2010 he moved to Australian Specialized Animal Pathology (ASAP Laboratory) joining a team of highly qualified veterinary pathologists and scientists. In January 2014 he became Managing Director of Orivet Genetic Pet Care and has a reputation of a Petrepreneur providing informative education seminars on companion animal genetics. “Genetic George” has continued to focus on educating breeders, vets, associations and pet owners on the benefits of DNA testing, in particular the insight it brings to dog and cat owners.
Webinare

Georgie Hollis
BSc

Georgie Hollis
BSc
Georgie Hollis BSc is an independent specialist in wound management and dressing technologies. She has lectured widely, both nationally and internationally across equine and small animal disciplines and has authored many peer reviewed articles across the UK and beyond.
Georgie's day to day role is focused on running the Veterinary Wound Library (<link http: www.vetwoundlibrary.com _blank>www.vetwoundlibrary.com). This site provides a resource for members to access specialist telemedicine support and further education in wound management.
Georgie also heads up her team of ‘Bandaging Angels’ who deliver tailored in house CPD to help practices refine their dressing selection and overcome their bandaging demons.
Georgie is an associate member of the BVNA, AVSTS, a member of EWMA (European wound management association) and past secretary of the Vet Wound Healing Association (VWHA).
Webinare

Gerry Skinner
DVM, BSc, BVSc, PhD, MRCVS, MANCVSc (emergency and critical care)

Gerry Skinner
DVM, BSc, BVSc, PhD, MRCVS, MANCVSc (emergency and critical care)
Gerry Skinner is the founder and co-director of the Rabbit Doctors clinic in Melbourne. She has been involved in the rabbit world all her life, and has been treating them as vet surgeon both in the UK and Australia for almost 20 years. She qualified from Bristol Vet School in 2003 after switching careers from archaeology / forensic anthropology and never looked back!
After initial emergency and exotics training in the UK she moved to Australia 15 years ago and kept emergency and critical care as her main clinical interest, gaining memberships in ECC and also managed a large Emergency Centre for several years. Nine years ago she set up her own clinic, where today the team of 28 see over 10,000 rabbit cases a year. Her special interests include emergency and critical care and neurological diseases in rabbits. She is passionate about rabbit welfare, teaching / training and spreading the news that rabbits are amazing pets to own, and although challenging, they are very satisfying to treat!
Webinare

Giselle Hosgood
BVSc, MS, PhD, FACVSc, Dipl. ACVS

Giselle Hosgood
BVSc, MS, PhD, FACVSc, Dipl. ACVS
Dr Hosgood is a registered specialist and Professor in Small Animal Surgery at Murdoch University. She has been practicing at The Animal Hospital at Murdoch University and teaching undergraduates and graduate veterinarians since arriving back in Australia in 2009, after 24 years training, teaching and practicing at Purdue University and Louisiana State University in the US. Dr Hosgood has extensive experience in soft tissue surgery and clinical research, with over 250 journal articles and book chapters published across species and disciplines, in part due to her interest in biostatistics.
Webinare

Graham Swinney
DVM, BVSc (Hons), DVCS, FANZCVSc

Graham Swinney
DVM, BVSc (Hons), DVCS, FANZCVSc
Graham graduated from the University of Sydney in 1987. He then moved to New Zealand where he was an Assistant Lecturer in Small Animal Medicine at Massey University from 1988-1990. From 1990-1991 he undertook a medical residency at the University of Queensland. Graham returned to the University of Sydney in 1993 where he was a Registrar in Small Animal Medicine. During this time, he achieved his Fellowship of the Australian and New Zealand College of Veterinary Scientists in Canine Medicine. From 1999 to 2005 Graham worked as a Clinical Track Assistant Professor at Washington State University. He returned to Sydney in 2005 and spent the next four years at the Veterinary Specialist Centre before returning to the University Veterinary Teaching Hospital Sydney (UVTHS) in 2009 as a Specialist in Canine Medicine. Since 2011 Graham has been at IDEXX Laboratories, working as an Internal Medicine Consultant and Medical Affairs Veterinarian. He has interests in clinical pathology, endocrinology and gastroenterology.
Webinare

Guillaume Chanoit
DVM, MSc, PhD, DECVS, DACVS. MRCVS

Guillaume Chanoit
DVM, MSc, PhD, DECVS, DACVS. MRCVS
Guillaume est diplômé forme l'école vétérinaire de Toulouse, France, où il a obtenu son diplôme DVM (avec thèse) en 1998. Guillaume est maître de conférence en chirurgie des tissus mous des petits animaux à l'Université de Bristol, école des sciences cliniques vétérinaires et membre de l'Institut de cardiologie de Bristol. Guillaume est également un rédacteur en chef adjoint (chirurgie des tissus mous) pour le Journal of Small Animal Practice. Il est également membre de la Commission d'examen de petits animaux du collège européen de chirurgie vétérinaire
Webinare

Guy Clare
DVM, MA, BVSc, CertVOphthal

Guy Clare
DVM, MA, BVSc, CertVOphthal
Dr Guy Clare graduated in December 1994 from the University of Liverpool. Following graduation he moved straight into small animal practice. 5 years later, together with his wife, they bought a first opinion practice in Bolton. He pursued an interest in ophthalmology gaining the RCVS Certificate in 2004. He ran a private referral practice in the UK and was the visiting ophthalmologist to Liverpool University where he had responsibility for teaching ophthalmology to clinical undergraduates. He has been in Australia since January 2009, working solely in small animal ophthalmology out of North Coast Veterinary Specialists, Queensland. Guy has delivered talks throughout his State and the UK and strives to bring a novel, memory-stimulating and informative approach to what is the most fascinating of veterinary disciplines.
A self-confessed perfectionist-obsessive his poor wife and children indulge and take part in his passion for sport, where he holds coaching qualifications in: rugby union, triathlon, weight lifting, horse riding and surf lifesaving. With respect to the latter Guy has been learning to ride a racing mal knee board (Bondi Rescue style). This he says has been a very sobering experience, but on the positive he won’t need to see an ENT specialist to have his sinuses flushed, as this regularly happens each time he goes out in the surf! If at first you don’t succeed…
Webinare

Hannah Capon
MA, VetMB, MRCVS, CCRP

Hannah Capon
MA, VetMB, MRCVS, CCRP
Hannah Capon MA Vet MB MRCVS CCRP, winner of the 2020 Royal College of Veterinary Surgeons Impact Award, the 2019 Ceva Vet of the Year and finalist in the 2019 Petplan Vet of the Year, is a first opinion veterinary surgeon in the UK. Recognised for her tireless work on Canine Arthritis Management (CAM) an online education and support service for owners of arthritic dogs and professionals that care for them.
Webinare

Hannah Kwong
DVM, B.V.Sc. (Hons)

Hannah Kwong
DVM, B.V.Sc. (Hons)
Hannah graduated with Bachelor of Veterinary Science (Hons) in 2012 through the University of Queensland. Since graduation, she has worked in a number of busy private practices in Brisbane. Hannah has an interest in medicine so in 2016 completed an external course through the University of Sydney in Small Animal Internal Medicine. Hannah started her residency in 2017 and has recently completed her training in mid-2019. During that time, she also obtained her Membership in Small Animal Medicine. She continues to work at Brisbane Veterinary Specialist Centre as an internal medicine registrar with the goal of sitting her Fellowship exams in 2021. Hannah’s special interests are in the areas of neurology, immune-mediated diseases, infectious disease and procedural medicine.